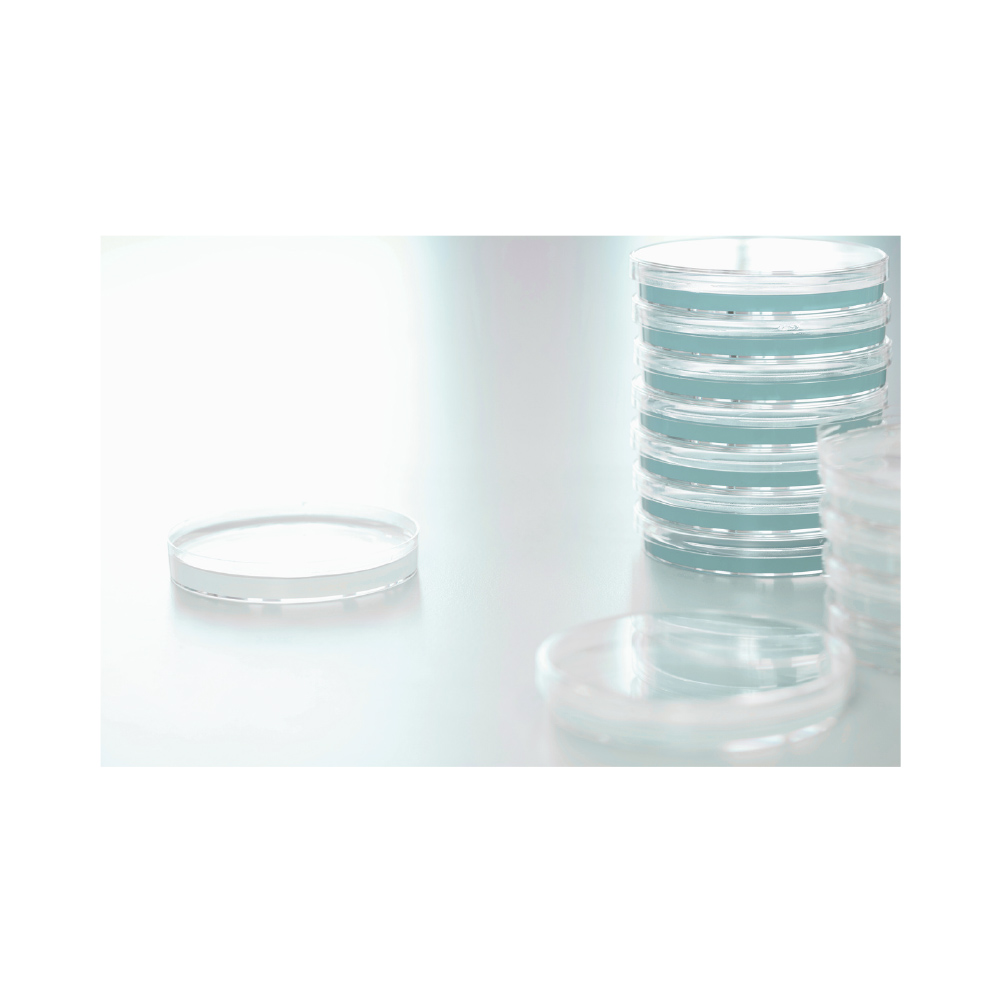

Caja Petri (Plástica y Vidrio)
Descripción
Utilizadas principalmente en microbiología para cultivar y observar microorganismos
como bacterias y hongos.
Material en Vidrio: Borosilicato 3.3.
Material en Plástico: Polietileno, estériles.
Medida en Vidrio: 100×20 mm
Medida en plástico: 60×15 mm y 90×15 mm.
Paquete de 10 unidades.